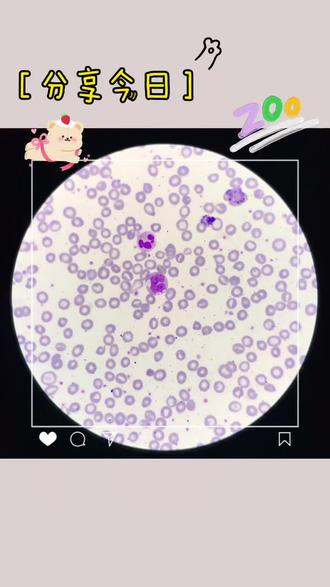
淋巴细胞最漂亮百变小魔女

淋巴细胞转化图片

淋巴细胞转化试验
图片尺寸671x251
淋巴细胞转化试验
图片尺寸314x376
常见脑脊液脱落细胞形态注意右上角的转化型淋巴细胞,可见明显的淡染
图片尺寸1068x986淋巴细胞转化
图片尺寸1200x803
淋巴细胞转化形态特征
图片尺寸920x518
分子医学实验t淋巴细胞转化试验ppt
图片尺寸960x720
who淋巴瘤分类基础:b淋巴细胞的分化演变及对应的淋巴瘤
图片尺寸1254x775
t淋巴细胞转化试验
图片尺寸449x208
淋巴细胞转化过程
图片尺寸680x510
淋巴细胞转化过程
图片尺寸680x510
首页 理论资料由于淋巴细胞是机体免疫系统的主要成分,故淋巴瘤也被
图片尺寸532x322
淋巴细胞转化过程
图片尺寸680x510
淋巴细胞转化
图片尺寸1080x810
如图所示为淋巴细胞的分化过程据图回答下列问题
图片尺寸1032x1002
t淋巴细胞是什么免疫
图片尺寸310x324
周小鸽教授解读:b淋巴细胞的分化过程
图片尺寸640x477
淋巴结转移
图片尺寸447x902
淋巴样肿瘤
图片尺寸702x448
blinatumomab 可致急性淋巴细胞白血病免疫表型转化
图片尺寸640x496
淋巴细胞最漂亮百变小魔女
图片尺寸330x587
猜你喜欢:淋巴细胞转化图怎么画淋巴细胞转化手绘图淋巴细胞转化图片手绘淋巴细胞转化淋巴细胞转化图淋巴细胞图片正常淋巴细胞图片淋巴细胞图片手绘图淋巴细胞镜下图片原始淋巴细胞图片幼稚淋巴细胞图片淋巴细胞卡通图片淋巴细胞转化实验t淋巴细胞转化试验图淋巴母细胞图片淋巴细胞和单核细胞淋巴细胞转化试验绘图淋巴细胞图片显微镜t淋巴细胞转化手绘图淋巴细胞结构图淋巴母细胞手绘图片淋巴细胞手绘图淋巴细胞转化红蓝铅笔淋巴细胞结构图手绘图淋巴细胞T淋巴细胞大淋巴细胞淋巴细胞分类淋巴母细胞手绘图原始淋巴细胞gta5地图全貌小茉莉吉他谱露肩 头像刘德华表情GIF释迦牟尼的坐骑图片斗鱼 手绘小智植物大战僵尸头像动物猫狗商标R标志太白山跑马梁红木联邦椅拘束装置